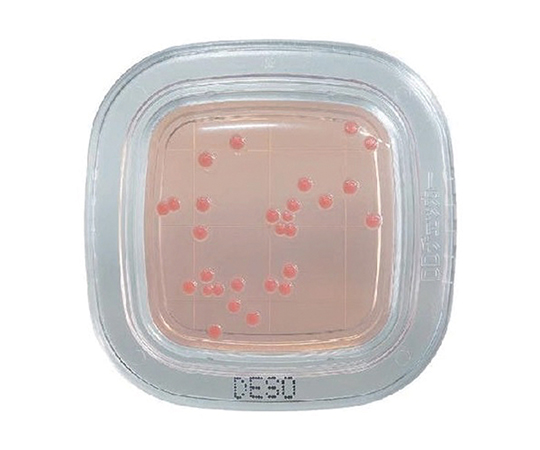
ぺたんチェックDD デオキシコレート寒天培地 1箱（100枚入） PD0004

|
商品番号
|
商品名・規格・入数 |
通常価格 |
販売価格
|
注文数 |
|

2-6430-40
製品番号:PD0006
|
-
 取寄せ
取寄せ
-
 冷蔵
冷蔵
ぺたんチェックDD X-GAL寒天培地 1箱(100枚入) PD0006
11箱(100枚入り)
(11箱(100枚入り)あたり14,550円(税込10% 16,005円))
|
- メーカー希望小売価格
-
15,000円
(税込 16,500円)
|
-
-
14,550 円
(税込 16,005 円)
|
ご注文にはログインが必要です
|
|

2-6430-39
製品番号:PD0005
|
-
 冷蔵
冷蔵
ぺたんチェックDD X-GAL寒天培地 1箱(20枚入) PD0005
11箱(20枚入り)
(11箱(20枚入り)あたり3,100円(税込10% 3,410円))
|
- メーカー希望小売価格
-
3,200円
(税込 3,520円)
|
-
-
3,100 円
(税込 3,410 円)
|
ご注文にはログインが必要です
|
|

2-6430-29
製品番号:PD0020
|
-
 取寄せ
取寄せ
-
 冷蔵
冷蔵
ぺたんチェックDD サブロー寒天培地 1箱(20枚入) PD0020
11箱(20枚入り)
(11箱(20枚入り)あたり3,100円(税込10% 3,410円))
|
- メーカー希望小売価格
-
3,200円
(税込 3,520円)
|
-
-
3,100 円
(税込 3,410 円)
|
ご注文にはログインが必要です
|
|

2-6430-34
製品番号:PD0004
|
-
 取寄せ
取寄せ
-
 冷蔵
冷蔵
ぺたんチェックDD デオキシコレート寒天培地 1箱(100枚入) PD0004
11箱(100枚入り)
(11箱(100枚入り)あたり14,550円(税込10% 16,005円))
|
- メーカー希望小売価格
-
15,000円
(税込 16,500円)
|
-
-
14,550 円
(税込 16,005 円)
|
ご注文にはログインが必要です
|
|
2-6430-23
製品番号:PD0003
|
-
 取寄せ
取寄せ
-
 冷蔵
冷蔵
ぺたんチェックDD デオキシコレート寒天培地 1箱(20枚入) PD0003
11箱(20枚入り)
(11箱(20枚入り)あたり3,100円(税込10% 3,410円))
|
- メーカー希望小売価格
-
3,200円
(税込 3,520円)
|
-
-
3,100 円
(税込 3,410 円)
|
ご注文にはログインが必要です
|
|

64-8070-22
製品番号:PA026
|
-
 取寄せ
取寄せ
ぺリスタポンプ(314D) PA026
11式
(11式あたり69,600円(税込10% 76,560円))
|
- メーカー希望小売価格
-
69,600円
(税込 76,560円)
|
-
-
69,600 円
(税込 76,560 円)
|
ご注文にはログインが必要です
|
|

64-8070-21
製品番号:PA025
|
-
 取寄せ
取寄せ
ぺリスタポンプ(314X) PA025
11式
(11式あたり69,600円(税込10% 76,560円))
|
- メーカー希望小売価格
-
69,600円
(税込 76,560円)
|
-
-
69,600 円
(税込 76,560 円)
|
ご注文にはログインが必要です
|
|

2-3627-01
製品番号:6585
|
まゆ毛取りシート 1袋(10枚×100シート入) 6585
11袋(10枚×100シート入り)
(11袋(10枚×100シート入り)あたり4,180円(税込10% 4,598円))
|
- メーカー希望小売価格
-
4,800円
(税込 5,280円)
|
-
-
4,180 円
(税込 4,598 円)
|
ご注文にはログインが必要です
|
|

4-1254-02
|
まゆ毛取りシール ディスペンサー ゴム付タイプ
11個
(11個あたり6,720円(税込10% 7,392円))
|
- メーカー希望小売価格
-
7,300円
(税込 8,030円)
|
-
-
6,720 円
(税込 7,392 円)
|
ご注文にはログインが必要です
|
|

4-1254-01
|
まゆ毛取りシール ディスペンサー 固定タイプ
11個
(11個あたり5,980円(税込10% 6,578円))
|
- メーカー希望小売価格
-
6,500円
(税込 7,150円)
|
-
-
5,980 円
(税込 6,578 円)
|
ご注文にはログインが必要です
|
|

4-1255-01
製品番号:ROLL 1000
|
まゆ毛取りシール(ロールタイプ)1巻(1000シート入) ROLL 1000
11巻(1000シート入り)
(11巻(1000シート入り)あたり4,000円(税込10% 4,400円))
|
- メーカー希望小売価格
-
4,600円
(税込 5,060円)
|
-
-
4,000 円
(税込 4,400 円)
|
ご注文にはログインが必要です
|
|

64-8070-82
製品番号:XMA-400
|
-
 取寄せ
取寄せ
アガートリコロール 400g XMA-400
11本
(11本あたり22,400円(税込10% 24,640円))
|
- メーカー希望小売価格
-
22,400円
(税込 24,640円)
|
-
-
22,400 円
(税込 24,640 円)
|
ご注文にはログインが必要です
|
|

64-8070-81
製品番号:XMA-01N
|
-
 取寄せ
取寄せ
アガートリコロール 7.85g XMA-01N
11箱
(11箱あたり18,000円(税込10% 19,800円))
|
- メーカー希望小売価格
-
18,000円
(税込 19,800円)
|
-
-
18,000 円
(税込 19,800 円)
|
ご注文にはログインが必要です
|
|

65-9404-56
製品番号:5042
|
-
 取寄せ
取寄せ
アキュディア(TM) ドリガルスキー改良培地 顆粒 300g 05042
11個(300g入り)
(11個(300g入り)あたり5,600円(税込10% 6,160円))
|
- メーカー希望小売価格
-
5,600円
(税込 6,160円)
|
-
-
5,600 円
(税込 6,160 円)
|
ご注文にはログインが必要です
|
|

63-5753-57
製品番号:5709
|
アキュディア(TM) ポテトデキストロース寒天培地 顆粒(カビ・酵母測定用) 300g 05709
11本
(11本あたり7,570円(税込10% 8,327円))
|
- メーカー希望小売価格
-
7,800円
(税込 8,580円)
|
-
-
7,570 円
(税込 8,327 円)
|
ご注文にはログインが必要です
|
|

63-5753-49
製品番号:5515
|
アキュディアTM R2A寒天培地 300 g 05515
11本
(11本あたり8,250円(税込10% 9,075円))
|
- メーカー希望小売価格
-
8,500円
(税込 9,350円)
|
-
-
8,250 円
(税込 9,075 円)
|
ご注文にはログインが必要です
|
|

63-5753-53
製品番号:5601
|
アキュディアTM TGC培地 顆粒 300 g 05601
11本
(11本あたり5,430円(税込10% 5,973円))
|
- メーカー希望小売価格
-
5,600円
(税込 6,160円)
|
-
-
5,430 円
(税込 5,973 円)
|
ご注文にはログインが必要です
|
|

63-5753-56
製品番号:5701
|
-
 取寄せ
取寄せ
アキュディアTM サブロー寒天培地 顆粒 300 g 05701
11本
(11本あたり4,370円(税込10% 4,807円))
|
- メーカー希望小売価格
-
4,500円
(税込 4,950円)
|
-
-
4,370 円
(税込 4,807 円)
|
ご注文にはログインが必要です
|
|

63-5753-54
製品番号:5610
|
-
 取寄せ
取寄せ
アキュディアTM チオグリコール酸培地Ⅱ 300 g 05610
11本
(11本あたり6,500円(税込10% 7,150円))
|
- メーカー希望小売価格
-
6,700円
(税込 7,370円)
|
-
-
6,500 円
(税込 7,150 円)
|
ご注文にはログインが必要です
|
|

63-5753-55
製品番号:5630
|
アキュディアTM トリプトソーヤブイヨン 顆粒(SCDブイヨン) 300 g 05630
11本
(11本あたり5,530円(税込10% 6,083円))
|
- メーカー希望小売価格
-
5,700円
(税込 6,270円)
|
-
-
5,530 円
(税込 6,083 円)
|
ご注文にはログインが必要です
|